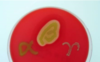

Bakterier Flashcards
(108 cards)
Vilka fyra morfologiska typer av bakterier finns det?
- Kocker, stavar, spiriller och spirochetter samt mellanting av dessa.
- Filament kan bildas av bakterier som inte fullständigt knoppas av, vanligen hos stavar

Obligat/strikt anaerob
- kan endast växa i frånvaro av syre (saknar enzymsystem för att oskadliggöra reaktiva syreradikaler)
Obligat/strikt aerob
Kan endast leva i närvaro av syre
Fakultativt anaerob
Kan leva i både närvaro och frånvaro av syre, men växer bättre i närvaro av syre.
Mikroaerofil
Tycker om låga nivåer av syre (lägre än vad som finns i luften)
På vilka sätt (7) påverkar två populationer av bakterier varandra?
- Obligat – nödvändig
- Mutualism – de kan inte delas upp utan kräver varandra

Varför färgas gramnegativa och grampostiva bakterier olika?
- Först färgas bakterien blå av kristallviolett.
- Därefter löser aceton upp membranet hos den gramnegativa där den blå färgen tvättas ur. Detta sker inte helt hos den grampositiva vars cellvägg är tjock och den förblir därför blå.
- Safarin tillsätts som röd färg vilket gör den gramnegativa röd till färgen och den grampositiva lila (Purple = Positive)
Hur är den gramnegativa bakterien uppbyggd?
- LPS-molekyler (lipopolysackarider) på yttre membran
- Yttre membran
-
Cellvägg
- Tunn peptidoglykan
- Periplasmatiskt utrymme (finns inte hos den positiva)
- Inre membran

Varför är gramnegativa bakterier mer känsliga för torra miljöer?
- Pga yttermembranet som hålls samman av hydrofoba krafter
- Därför tillhör de sällan normalfloran på huden utan oftare i mun/svalj, mag/tarmkanalen och andra fuktiga/blöta ställen
Vilka tre delar består LPS av?
- LPS består av en lipid, Lipid A som fäster LPS vid yttermembranet, Core-polysackaride (återkommande struktur) och ytterst Ospecifik-sackarid (även kallad O-antigen)
- O- antigen ger upphov till antikroppar
- Lipid A-delen är immunretande och ger via TLR-4 ett cytokinsvar med bla feber och akutfasproteiner

Vilka typer av bakterier kan bilda endosporer?
Grampositiva (inte alla)
Hur är en grampositiv bakterie uppbyggd?
-
Cellvägg
- Ttjockare peptidoglykan, lipoteikonsyra och teikonsyra
- Cellmembran

Nämn två sporbildare
Bacillus
Clostridium
Vilka två komponenter har peptidoglykan?
- N-acetylglukosamine (G)
- N-acetylmuraminsyra (M)
Hur sitter peptidoglykanens två komponenter (N-acetylglukosamine (G) och N-acetylmuraminsyra (M) ihop?
Beta(1,4)-bindningar

På vilka sätt skiljer sig peptidoglykan hos gramnegativa respektive grampositiva bakterier?
- Grampositiv har en glesare cellvägg, tjockare men mer porös struktur där större molekyler kan ta sig fram
- Gramnegativ mer kompakt
Vad är fimbrier?
- Virulensfaktor
- Gör att bakterier lättare fäster sig vid varandra eller andra organismers cellyta
- Större antal än pili men kortare
Vad är pili?
- Gör att baktierer lättare fäster sig vid varandra eller andra organismers cellyta
- Fungerar ofta som virusreceptor
- Behövs för konjugation
- Färre antal än fimbrie men längre
Glykokalyx
- Energidepå
- Kolhydrater utanför cellen
- Utanför yttre membranet (gramnegativ)
- Utanför peptidoglykanet (grampositiva)
- Bakterier som har dessa är ofta bra på att klibba fast, kan använda som bindning mot ytor (virulensfaktor)
Hur sker celldelning av bakterieren (övergripande)?
- DNA samlat i nukleoid, hålls samman av proteiner
- Förankras till cellytan vilket ger komplett genom i bägge dotterceller
- Plasmider replikeras självständigt och slumpen avgör vilken dottercell de hamnar i
- Efter DNA-replikering, syntes av cellvägg av makromolekyler i plasman, de släpper taget om varandra efter elongering, två dotterceller
- Generationstid (från replikering till celldelning) vanligt med generationstid under timmen för bakterier (selektiv fördel)

Vilka faser har bakteriens tillväxt?
- Lagfasen (anpassningfas till medie)
-
Exponentiell tillväxtfas (kort generatonstid och snabb ökning/dubblering)
- Generationstid anges vid exponentiell fas
-
Stationär fas, 4-10 h (varar ibland 0,5-1 dygn), lika många bakterier som dör som delar sig under platån, effekt av begränsningar i odlingsmediet
- Utrymme
- Näring
- Produktion av metaboliter, kan vara toxiska (hämmar egen tillväxt)
Deklinationsfas, fler bakterier dör än delar sig (1-flera dygn

Bakteriofag
Virus som endast infekterar bakterier
Hos vilka bakterier finns flageller?
Gramnegativa
Vad är flageller uppbyggt av?
Flagellin